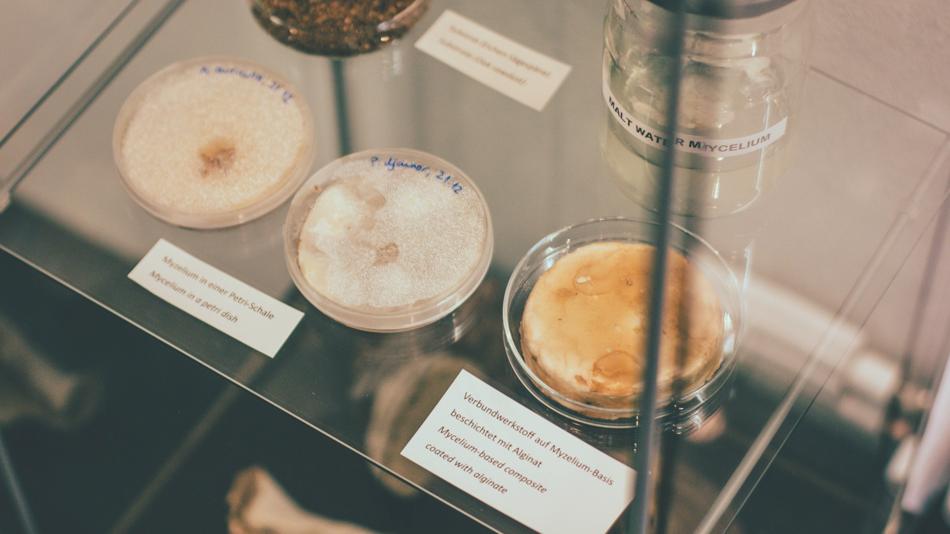
Materialexperimente

Experiment / Vorführung
Bauen mit Ziegeln und Pilzen?
Durchschnittliche Verweildauer: 20 Minuten
Maximale Kapazität der Station: 25 Personen
Die Station empfängt Besucher:innen im neu eröffneten ShapeLab des Instituts für Architektur und Medien (IAM) der TU Graz. Das Labor wurde im Rahmen des österreichweiten SFB-Projekts „Advanced Computational Design“ gegründet und dient als Forschungsplattform für digitale Fabrikation mit einem besonderen Schwerpunkt auf 3D-Druck mit Ton und bio-basierten Materialien als nachhaltige Alternativen im Bauwesen. Diese Forschung ist relevant, weil sie Wege zu ressourcenschonenderem, kreislauffähigem und klimafreundlicherem Bauen eröffnet.
Vor Ort können verschiedene digitale Fertigungstechnologien in Aktion erlebt werden – darunter ein industrieller Roboterarm, zwei großformatige 3D-Drucker im Baumodulmaßstab (ca. 2 m hoch) sowie ein monolithischer Gebäudedrucker (ca. 4 m hoch) für den Maßstab 1:1. Ergänzend werden Forschungs- und Lehrprototypen in unterschiedlichen Formen und Materialien präsentiert, die von Besucher:innen angefasst, erkundet und selbst erfahren werden können. Eine Ausstellung gibt Einblicke in den gesamten Forschungsprozess – von Materialaufbereitung und biologischem Wachstum bis hin zu digitaler Formgebung und Bauprozessen.
Besucherinformation
Anfahrtsbeschreibung: Kostenfreier Shuttlebus ab Jakominiplatz. Techniklinie C, Haltestelle C2. Der Standort ist auch mit dem öffentlichen Verkehr gut erreichbar: Straßenbahnlinie 6, Haltestelle Dietrichsteinplatz oder Neue Technik, Fahrtrichtung St. Peter. Am Campus der TU Graz stehen für Besucher:innen keine Parkplätze zur Verfügung.
Dieser Ausstellungsstandort ist barrierefrei zugänglich.
Öffnungszeiten
Beginnzeiten
Information
Zu jeder vollen Stunde gibt es einen kurzen Vortrag, und ein neuer großmaßstäblicher 3D-Druck wird gestartet (Roboter, 3D-Drucker mit 1m großen Objekt aus Ton, 2x 3D-Drucker mit 50cm großen Objekt aus Ton). Somit wird durchgehend 3D-Druck zu sehen sein.
Aus Sicherheits- und Platzgründen ist der Zugang auf maximal 25 Personen gleichzeitig begrenzt.